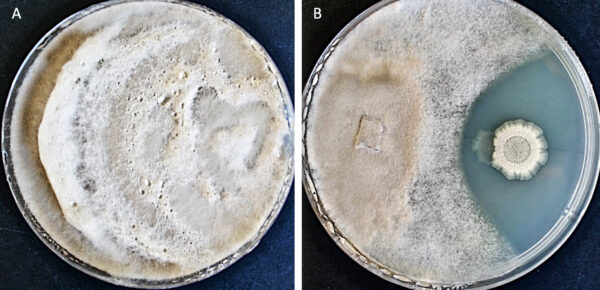

Datos de la empresa
Agroadvance es una compañía de biotecnología que investiga, desarrolla y comercializa herramientas innovadoras para la nutrición y sanidad vegetal. Desarrollamos productos que destacan por su calidad e inocuidad ambiental, logrando que las plantas desarrollen su potencial productivo, maximizando la rentabilidad de sus proyectos.
Productos: Bioestimulantes Microbianos, Línea Nutricionales, Línea Suelo y Bioestimulantes
Países: Chile y Perú
Página web: www.agroadvance.cl
Mail de contacto: czelaya@nsagro.cl
Teléfono de contacto: 981362464